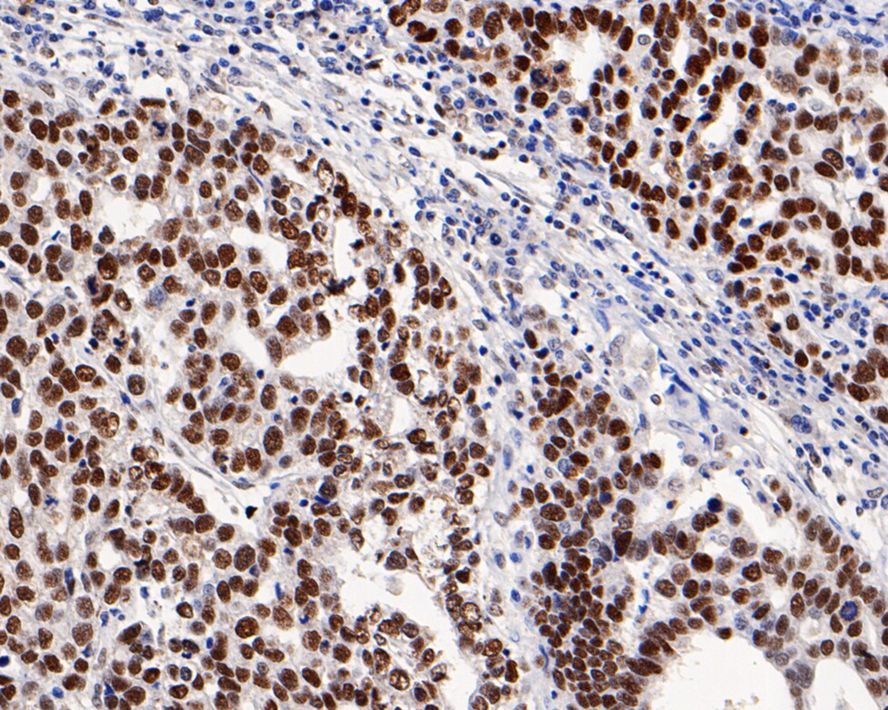

MSH2 Mouse Monoclonal Antibody(ARA725)
|
Application |
Dilution Ratio |
|
WB |
1:200-1:5000 |
|
IHC-P |
1:200-1:1000 |
|
Antibody Type |
Recombinant Mouse Monoclonal Antibody |
|
Immunogen |
Synthetic peptide within N-terminal residues of Human MSH2. |
|
Species Reactivity |
Human, Mouse, Rat |
|
Validated Applications |
WB, IHC-P |
|
Molecular Weight |
Predicted band size: 105 kDa |
|
Positive Control |
HeLa cell lysate, HEK-293 cell lysate, NIH/3T3 cell lysate, PC-12 cell lysate, Mouse testis tissue lysate, Rat testis tissue lysate, Daudi, human colon cancer tissue, human appendix tissue, human breast cancer tissue, human stomach cancer tissue, rat brain tissue, mouse large intestine tissue. |
|
Conjugation |
unconjugated |
|
Form |
Liquid |
|
Storage Buffer |
PBS (pH7.4), 0.1% BSA, 40% Glycerol. Preservative: 0.05% Sodium Azide. |
|
Isotype |
IgG1 |
|
Purification Method |
Protein A affinity purified. |

Immunohistochemical staining of human colon cancer tissue sections using MSH2 Mouse Monoclonal Antibody (ARA725).

Immunohistochemical staining of human stomach cancer tissue sections using MSH2 Mouse Monoclonal Antibody (ARA725).
 New Products
New Products